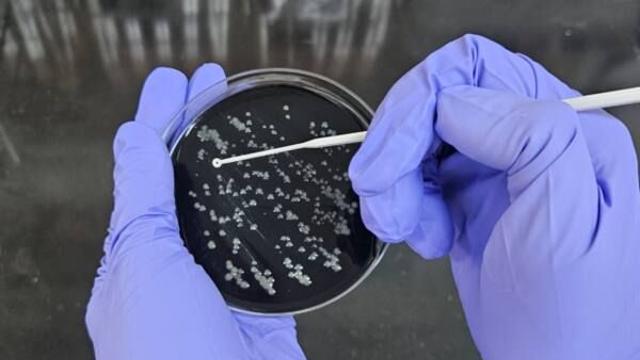
thumbimg

뉴스
- 정경자 의원, “장기요양요원지원센터 시군 단위 확대 시급”
- 뉴스영 2025.07.21
- 정경자 의원은 7월 18일, 경기도의회 남양주상담소에서 경기도사회서비스원에서 운영 중인 경
- 문턱 못 넘은 교육장관 후보들…"연구윤리 검증 강화" 목소리
- 이데일리 2025.07.21
- [이데일리 김응열 기자] 이진숙 교육부 장관 후보자가 결국 취임하지 못하고 물러났다. ‘제
- '청량리동→청량동' 동명칭 변경 주민의견 묻는다
- 연합뉴스 2025.07.21
- (서울=연합뉴스) 정준영 기자 = 동대문구(구청장 이필형)는 21일 '청량리동'(법정동 및
- MCM, 사이버-갤럭틱 노마드를 위한 AW25 컬렉션 공개
- 일간스포츠 2025.07.21
- 글로벌 럭셔리 패션 하우스 MCM이 사이버-갤럭틱 노마드를 위한(For Cyber-Gala
- 탑스텐 동강시스타, 골프장 18홀 증설
- 일간스포츠 2025.07.21
- SM그룹의 레저부문 계열사 탑스텐 리조트 동강시스타가 동강시스타 컨트리클럽(CC)의 코스를
- '아랍 삶 속으로 한 걸음 더' ACC서 만나는 아랍영화제
- 연합뉴스 2025.07.21
- '제14회 아랍영화제(Arab Film Festival)' 포스터 [국립아시아문화전당 제공
- 민생소비쿠폰 신청 첫날…신청 착오에 행안부 홈페이지 '먹통'
- 아주경제 2025.07.21
- 행안부. [사진=유대길 기자] 민생회복 소비쿠폰 신청 첫날, 일부 시민들이 절차를 제대
- 방글라데시, 관세율 낮추려 5년간 70만t씩 미국산 밀 수입키로
- 연합뉴스 2025.07.21
- 방글라데시 의류 공장 [로이터 연합뉴스 자료사진. 재판매 및 DB 금지] (서울=연합뉴스)
- 美국무 "미일 동맹, 번영의 초석"…미 언론 '극우' 참정당 약진 주목
- 이데일리 2025.07.21
- [이데일리 양지윤 김윤지 기자] 일본 여당이 20일 참의원(상원) 선거에서 과반 의석 유지
- '극한호우' 도심 홍수 반복되는 광주…"근본대책 고민해야"
- 연합뉴스 2025.07.21
- 2020년 집중호우로 인한 도심 홍수와 엇비슷…빗물 배수 안돼 큰 피해 우수저류시설 무용지
- 이종환 부산시의원, 아이돌봄 서비스 '신청 절차 간소화' 촉구
- 중도일보 2025.07.21
- 이종환 시의원./부산시의회 제공 부산시의회 이종환 의원(국민의힘·강서구)이 아이돌봄 지원사
- 동아오츠카, 육군사관학교 하계 군사훈련에 포카리스웨트 전달
- 일간스포츠 2025.07.21
- 동아오츠카는 2025년 육군사관학교 생도들의 하계 군사훈련에 포카리스웨트 4200개를 지원
- 30초면 뚝딱…소비쿠폰 직접 발급해보니
- 모두서치 2025.07.21
- 사진 = 뉴시스 이재명 정부가 21일 오전 9시부터 전 국민을 대상으로 '1차 민생회복
- SGA솔루션즈, 시스템 접근제어 자회사 SGN 합병
- 모두서치 2025.07.21
- 사진 = 뉴시스 SGA솔루션즈가 시스템 접근 제어 자회사 SGN을 흡수합병한다고 21일
- 코난테크놀로지 컨소시엄, '독자 AI' 정부 사업 참여
- 모두서치 2025.07.21
- 사진 = 뉴시스 인공지능(AI) 소프트웨어 전문기업 코난테크놀로지가 과학기술정보통신부가
- 동부건설, ‘개포현대4차’ 시공사 선정···“강남 프리미엄 주거 새 기준 제시”
- 직썰 2025.07.21
- 개포 현대4차 가로주택정비사업 조감도. [동부건설] [직썰 / 최소라 기자] 동부건설이 서
- 하천 준설 마친 대전, 물 폭탄에도 대규모 수해 없었다
- 이데일리 2025.07.21
- [대전=이데일리 박진환 기자] 충청권을 비롯해 전국에서 집중 호우에 따른 피해가 속출한 가
- 인천 동구, 대형시설 수질검사 추진…레지오넬라증 예방 나서
- 경기일보 2025.07.21
- 레지오넬라균 환경검사. 인천시 제공 인천 동구는 레지오넬라증 감염병 예방을 위해 최근
- 홍준표 “난파선 국힘, 몸부림 가엾다…자진 해산해야”
- 경기일보 2025.07.21
- 홍준표 전 대구시장이 지난 6월17일 인천국제공항 제1여객터미널을 통해 귀국, 취재진과 인
- 삼양식품 '잭앤펄스', '펄스랩'으로 재탄생
- 일간스포츠 2025.07.21
- 삼양식품은 잭앤펄스 브랜드를 ‘펄스랩(Pulse Lab)'으로 새롭게 선보인다고 21일 밝

경기
임병택 시흥시장, 시민과 함께 시흥교육의 현재를 고민하고, 미래를 그리다
김기보 / 25.11.28

대전/세종/충남
대전시의회 김영삼 부의장 “특수영상의 성장, 새로운 기회 이끌어”
김영란 / 25.11.28

대전/세종/충남
세종시교육청, 영유아교육과 보육의 방향 논의를 위한 ‘비전 워크숍’ 운영
김영란 / 25.11.28